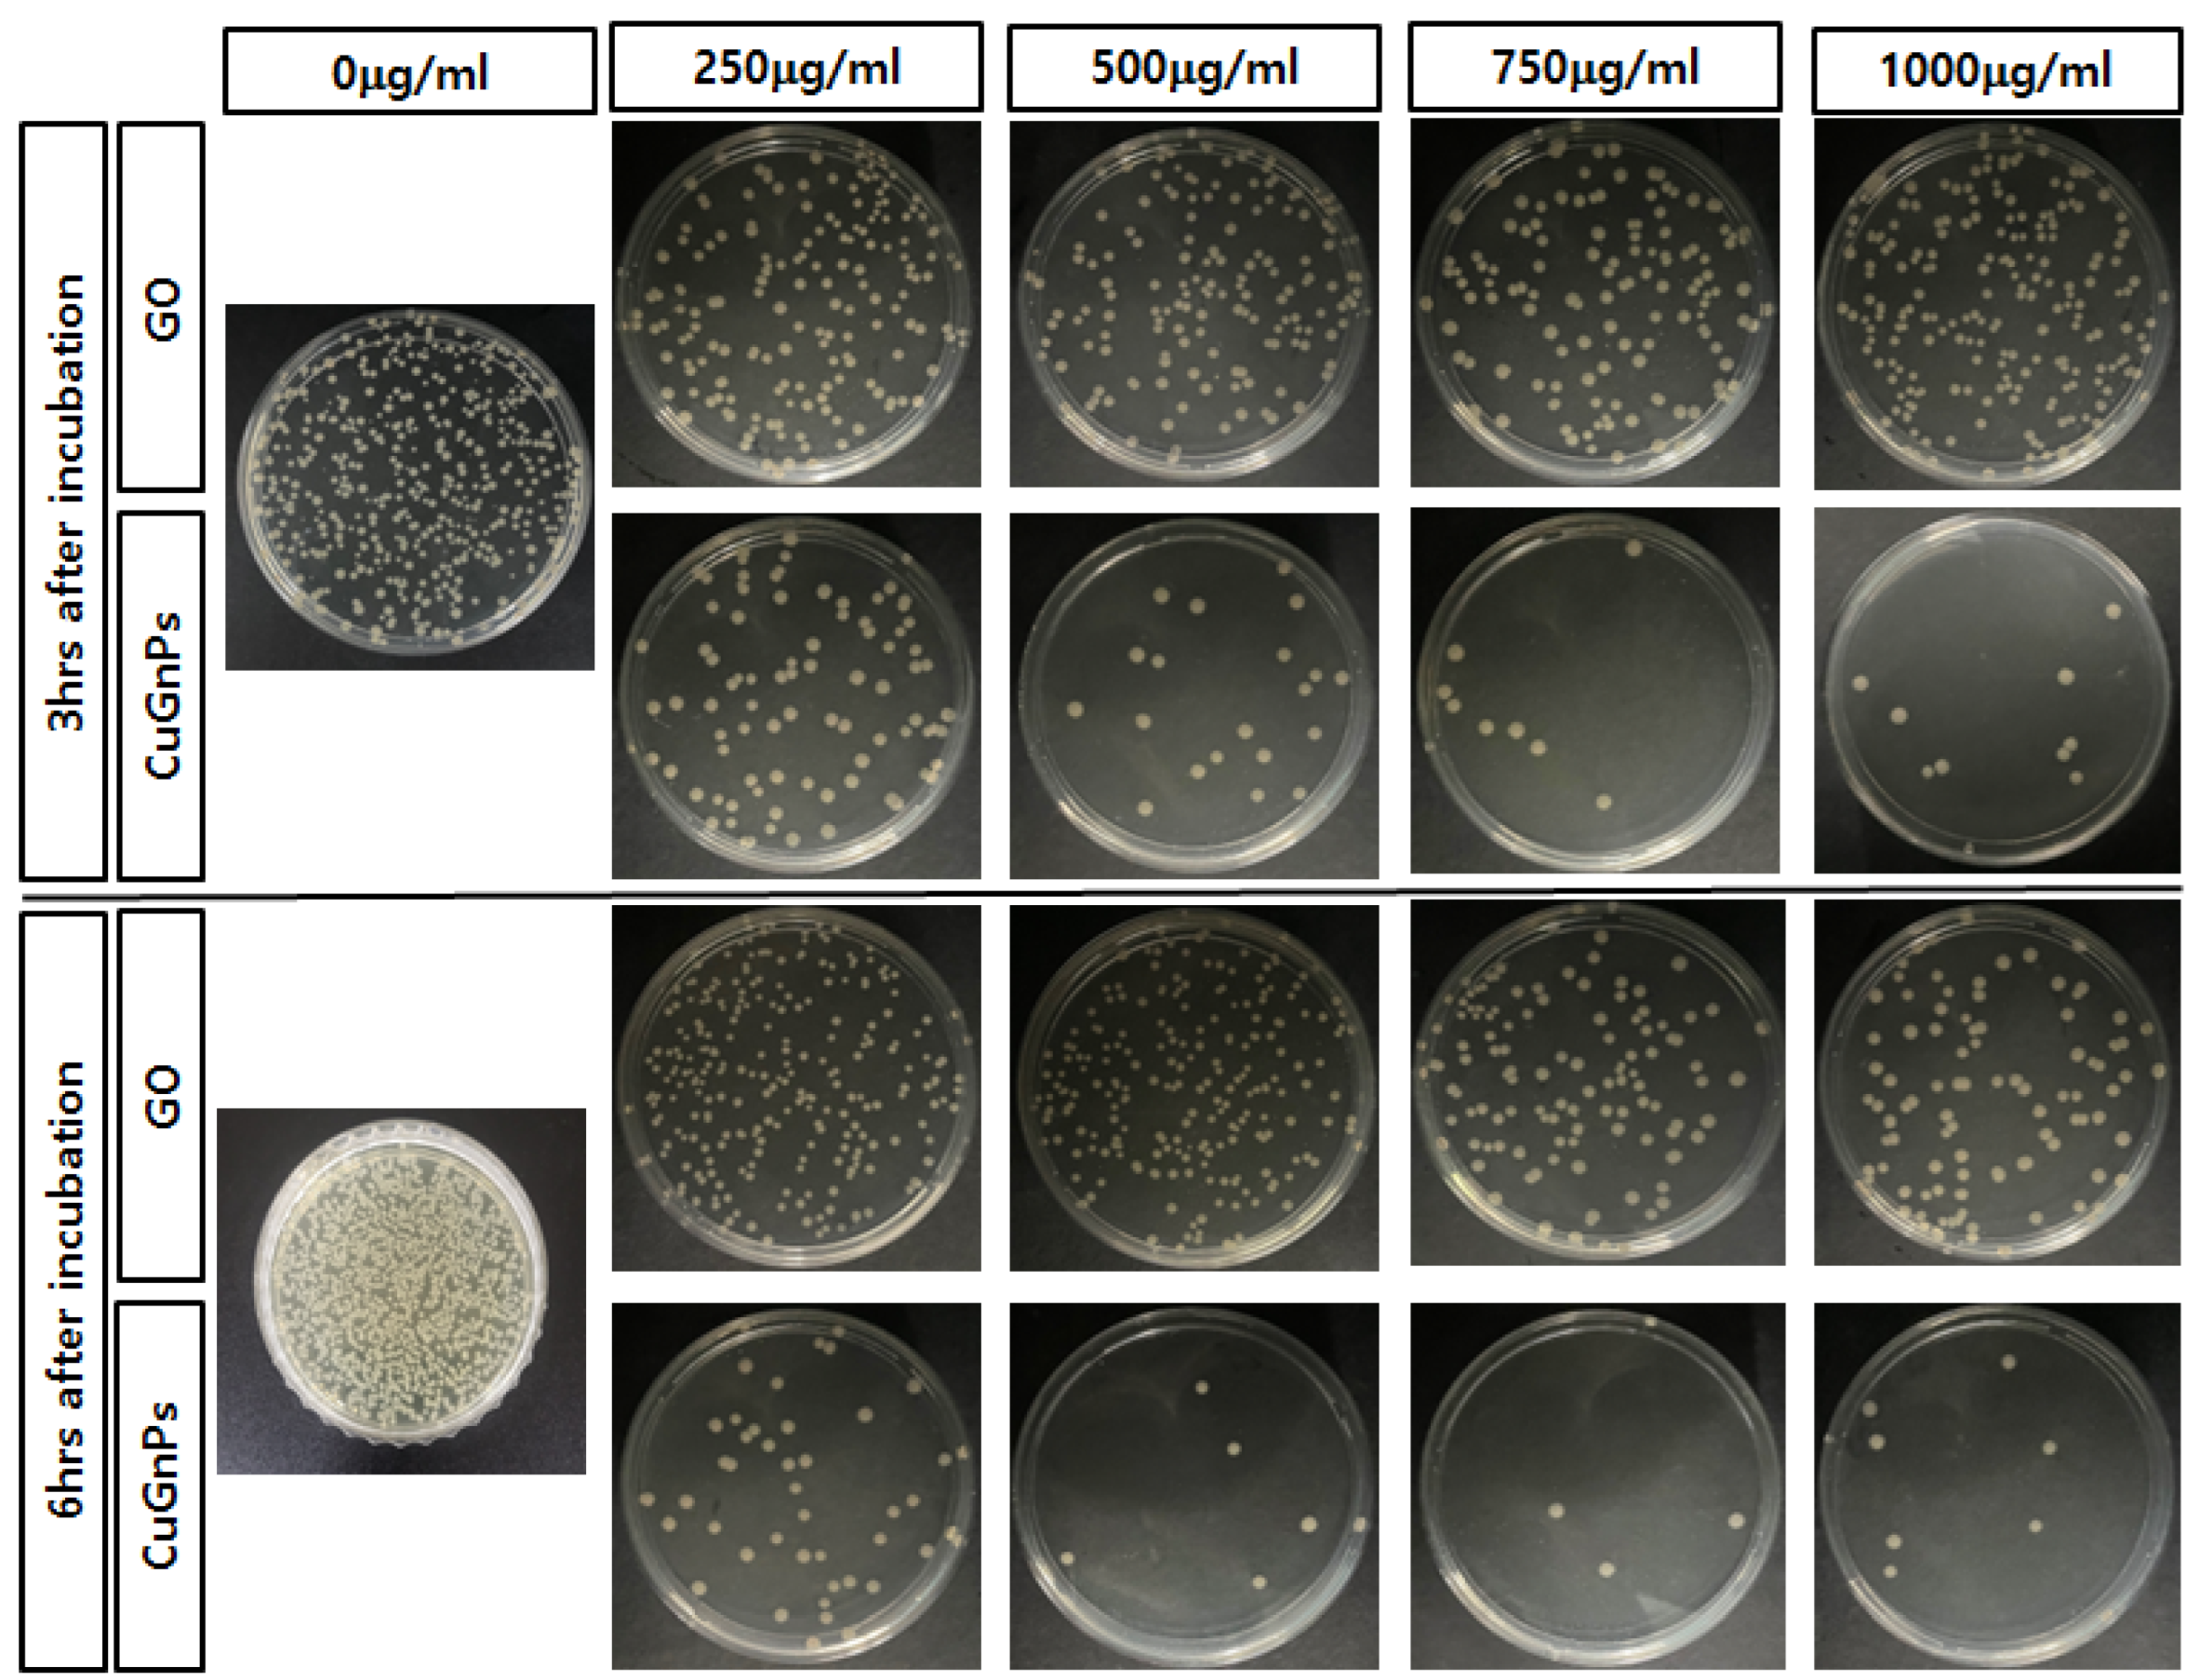
Ijms 25 12414 g006

Characterization of Antimicrobial Properties of Copper-Doped Graphitic Nanoplatelets
Abstract
1. Introduction
2. Results and Discussion
3. Experimental Section
3.1. Materials
3.2. Preparation of Copper-Doped Graphitic Nanoplatelets
3.3. Analytical Instruments
3.4. Bacterial Culture
3.5. Evaluation of Antibacterial Activity of Cu-Doped Graphitic Nanoplatelets
3.6. Preparation of Copper-Doped Graphitic Nanoplatelets and High-Density Polyethylene Film
3.7. Evaluation of Antibacterial Activity of Copper-Doped Graphitic Nanoplatelet Film
3.8. Statistical Analysis
4. Conclusions
Supplementary Materials
Author Contributions
Funding
Institutional Review Board Statement
Informed Consent Statement
Data Availability Statement
Conflicts of Interest
References
- Jiang, H.; Li, L.; Li, Z.; Chu, X. Metal-based nanoparticles in antibacterial application in biomedical field: Current development and potential mechanisms. Biomed. Microdevices 2024, 26, 12. [Google Scholar] [CrossRef] [PubMed]
- Franco, D.; Calabrese, G.; Guglielmino, S.P.P.; Conoci, S. Metal-Based Nanoparticles: Antibacterial Mechanisms and Biomedical Application. Microorganisms 2022, 10, 1778. [Google Scholar] [CrossRef] [PubMed]
- Stevanovic, M.; Djosic, M.; Jankovic, A.; Kojic, V.; Vukasinovic-Sekulic, M.; Stojanovic, J.; Odovic, J.; Crevar Sakac, M.; Kyong Yop, R.; Miskovic-Stankovic, V. Antibacterial graphene-based hydroxyapatite/chitosan coating with gentamicin for potential applications in bone tissue engineering. J. Biomed. Mater. Res. Part A 2020, 108, 2175–2189. [Google Scholar] [CrossRef] [PubMed]
- Geuli, O.; Metoki, N.; Zada, T.; Reches, M.; Eliaz, N.; Mandler, D. Synthesis, coating, and drug-release of hydroxyapatite nanoparticles loaded with antibiotics. J. Mater. Chem. B 2017, 5, 7819–7830. [Google Scholar] [CrossRef]
- Chen, Q.; Garcia, R.P.; Munoz, J.; Perez de Larraya, U.; Garmendia, N.; Yao, Q.; Boccaccini, A.R. Cellulose Nanocrystals—Bioactive Glass Hybrid Coating as Bone Substitutes by Electrophoretic Co-deposition: In Situ Control of Mineralization of Bioactive Glass and Enhancement of Osteoblastic Performance. ACS Appl. Mater. Interfaces 2015, 7, 24715–24725. [Google Scholar] [CrossRef]
- Patel, K.D.; Singh, R.K.; Lee, E.J.; Han, C.M.; Won, J.E.; Knowles, J.C.; Kim, H.W. Tailoring solubility and drug release from electrophoretic deposited chitosan-gelatin films on titanium. Surf. Coat. Technol. 2014, 242, 232–236. [Google Scholar] [CrossRef]
- Willyard, C. The drug-resistant bacteria that pose the greatest health threats. Nature 2017, 543, 15. [Google Scholar] [CrossRef]
- Li, T.; Ren, X.; Luo, X.; Wang, Z.; Li, Z.; Luo, X.; Shen, J.; Li, Y.; Yuan, D.; Nussinov, R.; et al. A Foundation Model Identifies Broad-Spectrum Antimicrobial Peptides against Drug-Resistant Bacterial Infection. Nat. Commun. 2024, 15, 7538. [Google Scholar] [CrossRef]
- Aviv, M.; Berdicevsky, I.; Zilberman, M. Gentamicin-loaded bioresorbable films for prevention of bacterial infections associated with orthopedic implants. J. Biomed. Mater. Res. Part A 2007, 83, 10–19. [Google Scholar] [CrossRef]
- Ramstedt, M.; Cheng, N.; Azzaroni, O.; Mossialos, D.; Mathieu, H.J.; Huck, W.T. Synthesis and characterization of poly(3-sulfopropylmethacrylate) brushes for potential antibacterial applications. Langmuir 2007, 23, 3314–3321. [Google Scholar] [CrossRef]
- Allison, B.C.; Applegate, B.M.; Youngblood, J.P. Hemocompatibility of hydrophilic antimicrobial copolymers of alkylated 4-vinylpyridine. Biomacromolecules 2007, 8, 2995–2999. [Google Scholar] [CrossRef] [PubMed]
- Li, Y.; Yuan, H.; von dem Bussche, A.; Creighton, M.; Hurt, R.H.; Kane, A.B.; Gao, H. Graphene microsheets enter cells through spontaneous membrane penetration at edge asperities and corner sites. Proc. Natl. Acad. Sci. USA 2013, 110, 12295–12300. [Google Scholar] [CrossRef] [PubMed]
- Yi, X.; Gao, H. Cell interaction with graphene microsheets: Near-orthogonal cutting versus parallel attachment. Nanoscale 2015, 7, 5457–5467. [Google Scholar] [CrossRef] [PubMed]
- Katwal, R.; Kaur, H.; Sharma, G.; Naushad, M.; Pathania, D. Electrochemical synthesized copper oxide nanoparticles for enhanced photocatalytic and antimicrobial activity. J. Ind. Eng. Chem. 2015, 31, 173–184. [Google Scholar] [CrossRef]
- Dalecki, A.G.; Haeili, M.; Shah, S.; Speer, A.; Niederweis, M.; Kutsch, O.; Wolschendorf, F. Disulfiram and Copper Ions Kill in a Synergistic Manner. Antimicrob. Agents Chemother. 2015, 59, 4835–4844. [Google Scholar] [CrossRef]
- Shams, S.; Ali, B.; Afzal, M.; Kazmi, I.; Al-Abbasi, F.A.; Anwar, F. Antifungal effect of Gatifloxacin and copper ions combination. J. Antibiot. 2014, 67, 499–504. [Google Scholar] [CrossRef]
- Manning, T.; Mikula, R.; Lee, H.; Calvin, A.; Darrah, J.; Wylie, G.; Phillips, D.; Bythell, B.J. The copper (II) ion as a carrier for the antibiotic capreomycin against. Bioor. Med. Chem. Lett. 2014, 24, 976–982. [Google Scholar] [CrossRef]
- Peng, C.; Zhang, S.; Sun, Z.; Ren, L.; Yang, K. Effect of annealing temperature on mechanical and antibacterial properties of Cu-bearing titanium alloy and its preliminary study of antibacterial mechanism. Mater. Sci. Eng. C Mater. Biol. Appl. 2018, 93, 495–504. [Google Scholar] [CrossRef]
- Dalecki, A.G.; Crawford, C.L.; Wolschendorf, F. Copper and Antibiotics: Discovery, Modes of Action, and Opportunities for Medicinal Applications. Adv. Microb. Physiol. 2017, 70, 193–260. [Google Scholar]
- Godoy-Gallardo, M.; Eckhard, U.; Delgado, L.M.; de Roo Puente, Y.J.D.; Hoyos-Nogues, M.; Gil, F.J.; Perez, R.A. Antibacterial approaches in tissue engineering using metal ions and nanoparticles: From mechanisms to applications. Bioact. Mater. 2021, 6, 4470–4490. [Google Scholar] [CrossRef]
- Jeon, I.Y.; Choi, M.; Choi, H.J.; Jung, S.M.; Kim, M.J.; Seo, J.M.; Bae, S.Y.; Yoo, S.; Kim, G.; Jeong, H.Y.; et al. Antimony-doped graphene nanoplatelets. Nat. Commun. 2015, 6, 7123. [Google Scholar] [CrossRef] [PubMed]
- Chaudhuri, B.; Bhadra, D.; Moroni, L.; Pramanik, K. Myoblast differentiation of human mesenchymal stem cells on graphene oxide and electrospun graphene oxide-polymer composite fibrous meshes: Importance of graphene oxide conductivity and dielectric constant on their biocompatibility. Biofabrication 2015, 7, 015009. [Google Scholar] [CrossRef] [PubMed]
- Rajapaksha, P.; Cheeseman, S.; Hombsch, S.; Murdoch, B.J.; Gangadoo, S.; Blanch, E.W.; Truong, Y.; Cozzolino, D.; McConville, C.F.; Crawford, R.J.; et al. Antibacterial Properties of Graphene Oxide-Copper Oxide Nanoparticle Nanocomposites. ACS Appl. Bio Mater. 2019, 2, 5687–5696. [Google Scholar] [CrossRef] [PubMed]
- Yang, F.; Huo, D.; Zhang, J.; Lin, T.; Zhang, J.; Tan, S.; Yang, L. Fabrication of graphene oxide/copper synergistic antibacterial coating for medical titanium substrate. J. Colloid Interface Sci. 2023, 638, 1–13. [Google Scholar] [CrossRef] [PubMed]
- Kiani, F.; Astani, N.A.; Rahighi, R.; Tayyebi, A.; Tayebi, M.; Khezri, J.; Hashemi, E.; Rothlisberger, U.; Simchi, A. Effect of graphene oxide nanosheets on visible light-assisted antibacterial activity of vertically-aligned copper oxide nanowire arrays. J. Colloid Interface Sci. 2018, 521, 119–131. [Google Scholar] [CrossRef]
- Wang, Y.T.; Lü, Y.Y.; Zhan, W.W.; Xie, Z.X.; Kuang, Q.; Zheng, L.S. Synthesis of porous CuO/CuO cages using Cu-based metal-organic frameworks as templates and their gas-sensing properties. J. Mater. Chem. A 2015, 3, 12796–12803. [Google Scholar] [CrossRef]
- Audi, G.; Bersillon, O.; Blachot, J.; Wapstra, A.H. The NUBASE evaluation of nuclear and decay properties. Nucl. Phys. A 2003, 729, 3–128. [Google Scholar] [CrossRef]
- Kruk, M.; Jaroniec, M.; Gadkaree, K.P. Nitrogen Adsorption Studies of Novel Synthetic Active Carbons. J. Colloid Interface Sci. 1997, 192, 250–256. [Google Scholar] [CrossRef]
- Fang, Y.; Gu, D.; Zou, Y.; Wu, Z.X.; Li, F.Y.; Che, R.C.; Deng, Y.H.; Tu, B.; Zhao, D.Y. A Low-Concentration Hydrothermal Synthesis of Biocompatible Ordered Mesoporous Carbon Nanospheres with Tunable and Uniform Size. Angew. Chem. Int. Ed. 2010, 49, 7987–7991. [Google Scholar] [CrossRef]
- Zhang, X.T.; Kong, H.; Yang, G.Z.; Zhu, D.Z.; Luan, X.; He, P.; Wei, G. Graphene-Based Functional Hybrid Membranes for Antimicrobial Applications: A Review. Appl. Sci. 2022, 12, 4834. [Google Scholar] [CrossRef]
- Xia, M.Y.; Xie, Y.; Yu, C.H.; Chen, G.Y.; Li, Y.H.; Zhang, T.; Peng, Q. Graphene-based nanomaterials: The promising active agents for antibiotics-independent antibacterial applications. J. Control. Release 2019, 307, 16–31. [Google Scholar] [CrossRef] [PubMed]
- Jeon, I.Y.; Shin, Y.R.; Sohn, G.J.; Choi, H.J.; Bae, S.Y.; Mahmood, J.; Jung, S.M.; Seo, J.M.; Kim, M.J.; Chang, D.W.; et al. Edge-carboxylated graphene nanosheets via ball milling. Proc. Natl. Acad. Sci. USA 2012, 109, 5588–5593. [Google Scholar] [CrossRef] [PubMed]
- Jeon, I.Y.; Choi, H.J.; Jung, S.M.; Seo, J.M.; Kim, M.J.; Dai, L.M.; Baek, J.B. Large-Scale Production of Edge-Selectively Functionalized Graphene Nanoplatelets via Ball Milling and Their Use as Metal-Free Electrocatalysts for Oxygen Reduction Reaction. J. Am. Chem. Soc. 2013, 135, 1386–1393. [Google Scholar] [CrossRef] [PubMed]
- Boi, F.S.; Liu, M.J.; Xia, J.C.; Odunmbaku, O.; Taallah, A.; Wen, J.Q. Anomalous c-axis shifts and symmetry enhancement in highly oriented pyrolytic graphite at the magic angle. Carbon 2019, 150, 27–31. [Google Scholar] [CrossRef]
- Chen, J.H.; Ren, S.B.; He, X.B.; Qu, X.H. Properties and microstructure of nickel-coated graphite flakes/copper composites fabricated by spark plasma sintering. Carbon 2017, 121, 25–34. [Google Scholar] [CrossRef]
- Ma, X.R.; Zhou, S.Y.; Xu, X.L.; Du, Q. Copper-containing nanoparticles: Mechanism of antimicrobial effect and application in dentistry-a narrative review. Front. Surg. 2022, 9, 905892. [Google Scholar] [CrossRef]
- Ramos-Zúñiga, J.; Bruna, N.; Pérez-Donoso, J.M. Toxicity Mechanisms of Copper Nanoparticles and Copper Surfaces on Bacterial Cells and Viruses. Int. J. Mol. Sci. 2023, 24, 10503. [Google Scholar] [CrossRef]
- Salah, I.; Parkin, I.P.; Allan, E. Copper as an antimicrobial agent: Recent advances. RSC Adv. 2021, 11, 18179–18186. [Google Scholar] [CrossRef]
- Smith, S.C.; Rodrigues, D.F. Carbon-based nanomaterials for removal of chemical and biological contaminants from water: A review of mechanisms and applications. Carbon 2015, 91, 122–143. [Google Scholar] [CrossRef]
- Kumar, P.; Huo, P.P.; Zhang, R.Z.; Liu, B. Antibacterial Properties of Graphene-Based Nanomaterials. Nanomaterials 2019, 9, 737. [Google Scholar] [CrossRef]
- Zhu, Y.W.; Murali, S.; Cai, W.W.; Li, X.S.; Suk, J.W.; Potts, J.R.; Ruoff, R.S. Graphene and Graphene Oxide: Synthesis, Properties, and Applications. Adv. Mater 2010, 22, 3906–3924. [Google Scholar] [CrossRef] [PubMed]
- Zanni, E.; Bruni, E.; Chandraiahgari, C.R.; De Bellis, G.; Santangelo, M.G.; Leone, M.; Bregnocchi, A.; Mancini, P.; Sarto, M.S.; Uccelletti, D. Evaluation of the antibacterial power and biocompatibility of zinc oxide nanorods decorated graphene nanoplatelets: New perspectives for antibiodeteriorative approaches. J. Nanobiotechnol. 2017, 15, 57. [Google Scholar] [CrossRef] [PubMed]
- Kang, Y.A.; Kim, M.H.; Noh, H.J.; Baek, J.B.; Jeon, I.Y. Reinforcement of polystyrene using edge-styrene graphitic nanoplatelets. J. Mater. Res. Technol. 2021, 10, 662–670. [Google Scholar] [CrossRef]

Disclaimer/Publisher’s Note: The statements, opinions and data contained in all publications are solely those of the individual author(s) and contributor(s) and not of MDPI and/or the editor(s). MDPI and/or the editor(s) disclaim responsibility for any injury to people or property resulting from any ideas, methods, instructions or products referred to in the content. |
© 2024 by the authors. Licensee MDPI, Basel, Switzerland. This article is an open access article distributed under the terms and conditions of the Creative Commons Attribution (CC BY) license (https://creativecommons.org/licenses/by/4.0/).
Share and Cite
Kang, J.-K.; Yoon, S.J.; Park, H.; Lee, S.-J.; Baek, J.; Jeon, I.-Y.; Gwak, S.-J. Characterization of Antimicrobial Properties of Copper-Doped Graphitic Nanoplatelets. Int. J. Mol. Sci. 2024, 25, 12414. https://doi.org/10.3390/ijms252212414
Kang J-K, Yoon SJ, Park H, Lee S-J, Baek J, Jeon I-Y, Gwak S-J. Characterization of Antimicrobial Properties of Copper-Doped Graphitic Nanoplatelets. International Journal of Molecular Sciences. 2024; 25(22):12414. https://doi.org/10.3390/ijms252212414
Chicago/Turabian StyleKang, Jun-Kyu, Seo Jeong Yoon, Honghyun Park, Seung-Jae Lee, Jaehoon Baek, In-Yup Jeon, and So-Jung Gwak. 2024. "Characterization of Antimicrobial Properties of Copper-Doped Graphitic Nanoplatelets" International Journal of Molecular Sciences 25, no. 22: 12414. https://doi.org/10.3390/ijms252212414
APA StyleKang, J.-K., Yoon, S. J., Park, H., Lee, S.-J., Baek, J., Jeon, I.-Y., & Gwak, S.-J. (2024). Characterization of Antimicrobial Properties of Copper-Doped Graphitic Nanoplatelets. International Journal of Molecular Sciences, 25(22), 12414. https://doi.org/10.3390/ijms252212414





